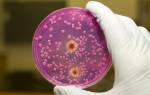

В настоящее время любой может создать сайт или блог, оптимизировать его и просто зарабатывать на этом деньги. Вам просто нужна новаторская идея и небольшие усилия. Создание веб-сайта даже не потребует вложений. Большинство подростков, в основном изучающих информатику, берутся за работу в этом бизнесе, чтобы получить навыки, которые могут принести им много денег во время учебы. Итак, ниже будет представлено несколько советов о том, как создать веб-сайт. Также для создания качественного сайта можно обратиться в специализированную компанию, например, https://xn—-7sbbaqhlkm9ah9aiq.net/sozdanie-saytov-ukraine/odessa/
1. Выбор доменного имени
Если вы будете продавать что-то в интернете или создать популярный новостной портал, то выбор доменного имени имеет первостепенное значение. Он должен быть очень броским и коротким, чтобы к нему мог привыкнуть любой посетитель. Например, Facebook раньше назывался thefacebook, и один из основателей удалил «the», чтобы сделать название кратким и запоминающимся.
Таким образом, вы должны придумать доменное имя, чтобы ваши посетители с первого взгляда понимали, что их ждет на сайте.
Создание качественного сайта требует внимательного подхода и учета мнений специалистов. Врачи подчеркивают важность удобства навигации и интуитивно понятного интерфейса. Они отмечают, что пользователи должны легко находить нужную информацию, особенно если речь идет о медицинских услугах. Также важно обеспечить адаптивность сайта для мобильных устройств, так как многие пациенты используют смартфоны для поиска информации.
Кроме того, врачи акцентируют внимание на необходимости актуального и достоверного контента. Информация должна быть написана простым языком, чтобы ее могли понять все пользователи, независимо от уровня образования. Наличие раздела с часто задаваемыми вопросами и контактной информацией также способствует повышению доверия к ресурсу.
Не менее важным аспектом является безопасность данных пользователей. Врачи рекомендуют использовать современные технологии шифрования и защищенные формы обратной связи, чтобы гарантировать конфиденциальность. Таким образом, качественный сайт не только привлекает внимание, но и создает комфортные условия для взаимодействия с пациентами.
![Как сделать сайт с нуля за 5 минут БЕЗ программирования [пошаговая инструкция]](https://i.ytimg.com/vi/1gpJI8cupTo/maxresdefault.jpg)
2. Покупка хостинга
Хороший хостинг стоит около 60-80 долларов. Однако, на первых этапах не стоит тратить на это деньги.
Есть много бесплатных хостинг-провайдеров, которые предлагают ограниченные возможности. Если вы уверены в том, что сайт станет популярным и знаете, как купить премиальный хостинг, попробуйте вложить в это деньги.
3. Наличие базовых навыков
Если вы хотите серьезно создать веб-сайт и сделать с ним что-то необычное, вам необходимо иметь некоторые базовые навыки перед созданием веб-сайта, такие как html, css, jquery, javascript, php, а также некоторые общие технические навыки. Эти навыки помогут вам создать свой сайт быстрее, чем вы ожидаете.
Создание качественного сайта — это задача, которая требует внимательного подхода и понимания потребностей пользователей. Многие эксперты советуют начинать с четкого определения цели сайта и его целевой аудитории. Важно, чтобы дизайн был интуитивно понятным и привлекательным, так как первое впечатление играет ключевую роль. Также стоит обратить внимание на адаптивность — сайт должен корректно отображаться на различных устройствах.
Содержание — это еще один важный аспект. Пользователи ценят уникальный и полезный контент, который отвечает на их вопросы. Оптимизация для поисковых систем (SEO) также не должна оставаться в стороне, так как это помогает привлечь органический трафик. Наконец, регулярное обновление и поддержка сайта обеспечивают его актуальность и функциональность. В итоге, качественный сайт — это гармоничное сочетание дизайна, контента и технологий.

4. Написание качественного контента
После того, как ваш сайт создан, вы не должны вести его таким образом, чтобы извлечь из него выгоду. Вам нужно много работать, создавать уникальный контент, но не копировать его. Пользователи должны почувствовать разницу между ценностью коонтента на вашем сайте и на других. Также, нужно соблюдать политику Google, поскольку Google очень строг к сайтам, которые размещают скопированный текст.
Создание уникального контента поможет вам получить больше трафика и лояльных читателей, а также окупится, когда вы начнете монетизировать свой сайт.
5. Поддержание правильной навигации
После того, как вы закончите создание своего веб-сайта, следующая часть — разработать его в соответствии с вашим доменным именем, использовать простые настройки и обеспечить правильную навигацию, чтобы читатель мог легко понять и просмотреть сайт как можно быстрее. Оптимизируйте свой сайт для SEO, используя внутренние ссылки и наполняя посты ключевыми словами.

Вопрос-ответ
Что нужно для создания хорошего сайта?
Дизайн Разработку дизайна начинают с подбора цветов, гармонирующих друг с другом. Вёрстка Вёрстка представляет собой перевод готового макета (картинки) в HTML и CSS код. Программирование Контент HTML и CSS. Визуальные редакторы Конструкторы CMS.
Сколько стоит сделать хороший сайт?
Цена создания многостраничного сайта начинается от 100 000 рублей за проекты с базовым дизайном и функционалом. Для более сложных проектов с уникальными дизайнерскими решениями, расширенной функциональностью и SEO-оптимизацией цена может достигать 500 000 рублей и более.
Сколько денег дают за создание сайта?
Новичкам в штате редко платят больше 30-40 тысяч рублей, middle разработчики могут рассчитывать на 60-70 тысяч, а более опытные специалисты получают больше 100 тысяч в месяц. На фрилансе средних показателей нет. В хорошие месяцы доход фрилансера со средним уровнем может составлять и 200-300 тысяч рублей.
Советы
СОВЕТ №1
Определите цель вашего сайта. Прежде чем начать разработку, четко сформулируйте, какую задачу он должен решать: информировать, продавать, развлекать или что-то другое. Это поможет вам сосредоточиться на нужном контенте и функционале.
СОВЕТ №2
Выберите удобный и интуитивно понятный дизайн. Пользователи должны легко ориентироваться на вашем сайте. Используйте понятные меню, четкую навигацию и адаптивный дизайн, чтобы ваш сайт выглядел хорошо на всех устройствах.
СОВЕТ №3
Обеспечьте качественный контент. Наполняйте сайт уникальными и полезными материалами, которые будут интересны вашей целевой аудитории. Регулярно обновляйте контент, чтобы поддерживать интерес пользователей и улучшать SEO-позиции.
СОВЕТ №4
Не забывайте об оптимизации для поисковых систем (SEO). Используйте ключевые слова, мета-теги и описания, чтобы ваш сайт был виден в поисковых системах. Это поможет привлечь больше посетителей и повысить видимость вашего сайта в интернете.